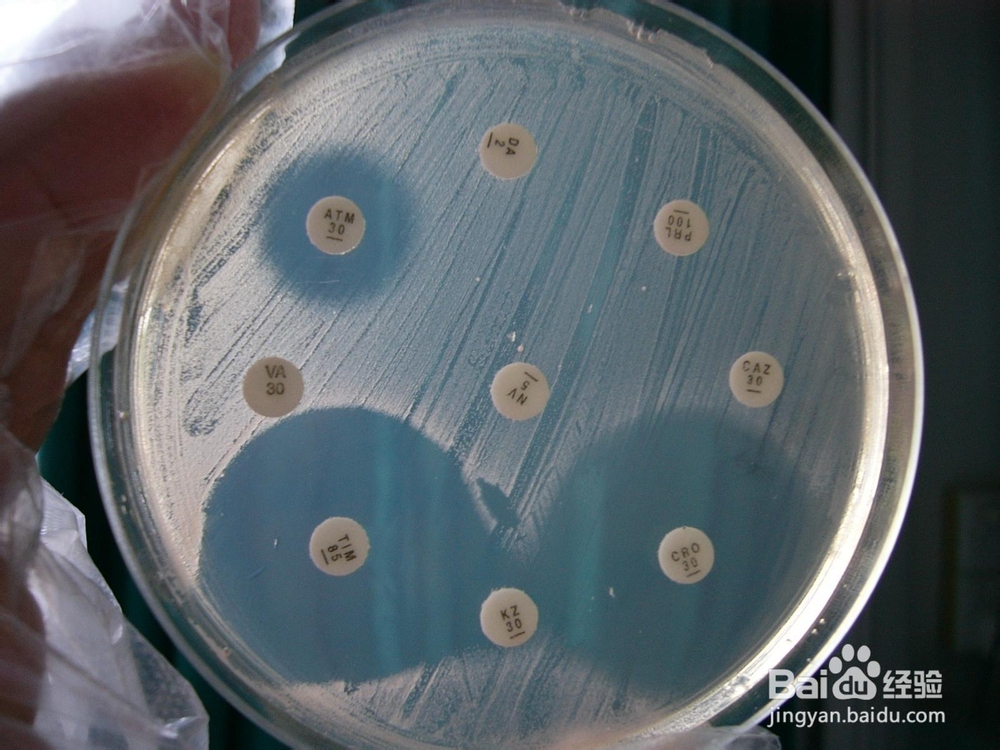
2014年执业药师考试辅导之合理使用抗生素

2014年执业药师考试辅导之合理使用抗生素
1、1.抗生素使用原则——病毒感染,如感冒、流感等不宜使用抗生素。

2、2.发热待查(除非病情严重,临床经验高度怀疑细菌感染者)不宜使用抗生素。
3、 3.皮肤及粘膜等局部应尽量避免使用抗生素,以免引起耐药菌产生或变态反应。
4、 4.青霉素(G):是第一个发现的抗生素,肺炎球菌、A组溶血性链球菌及脆弱类杆菌的厌氧菌感染等仍属首选药物。
5、 5.抗生素使用原则——大环内酯类:宜用于轻度、中度呼吸道感染、支原体及衣原体感染。
6、 6.氨基糖甙类:每日一次加10%葡萄糖液100ml,静滴疗效好,毒性小、不易产生耐药菌株,宜用于G-杆菌感染、金黄色葡萄球菌感染等,疗程约7天。要注意其能引起耳、肾毒性。
7、 7.喹诺酮类:多适用于尿路感染、肠道感染及轻度、中度呼吸道感染。
8、 8.抗生素使用原则——头孢菌素:除第一代、某些第二代及口服制剂外,一般属于非首选药物。如属于中度及重度医院内感染可用第三代头孢菌素,属于医院内重症感染、重症混合感染(需氧菌及厌氧菌)、免疫功能低下病人可考虑用泰能。
9、 9.最好按细菌药敏试验结果选药。要熟悉选用药物的抗菌活性、药效学及药动学。
10、 10.当一种抗菌药物能控制感染时,尽可能不采取联用,减少不必要的使用抗菌药物。
11、 11.单一抗菌药物无效时或重度感染病人,可按药敏试验选用两种抗菌药物联用,一般不联用三种以上的抗菌药物。
12、 12.抗生素使用原则——静滴抗生素比口服抗生素贵,如病情许可应口服抗生素。

13、 13.严重感染的病人初期需要静滴抗生素,待病情稳定后可改用相同口服抗生素。
14、 14.重症感染者如用头孢他定及泰能可考虑经验治疗。在某些临床情况下也可考虑次强广谱抗生素如头孢哌酮,这样可延长前者的抗菌性。
15、 15.抗生素使用原则——要严格掌握万古霉素适应症,①由耐β—内酰胺抗生素的G+球菌引起的严重感染。②G+球菌感染病人对β—内酰胺抗生素严重过敏;③抗生素相关肠炎患者,用甲硝唑治疗无效,或病情十分严重,并有危及生命的可能等再用该抗生素。
16、 16.如遇两种抗生素对同一种细菌敏感时,则选其中便宜的。
17、 17.一般急性感染。抗生素在体温恢复正常,症状消失后继续用2~3天。急性感染病程不易迁延者(如急性肠炎),病情基本控制后1~3即可停药。G+球菌肺炎;退热后3~5天,金葡菌肺炎疗程需要稍长可停药。G-杆菌肺炎;退热后5~7天可停药。尿路感染;疗程3~5天,反复发作者稍延长。败血症;病情好转,体温正常7~10天后再停药。
18、 18.急性感染,应用抗生素后临床疗效不显著,一般在72小时应考虑改用其他抗菌药物。
19、 19.外科预防性用药:一般而言可在手术前30分钟预防性给药。

20、 20.对新药、高档药的商品名、化学名与现有的抗生素对照,是否原有的抗生素改变了商品名。必须熟悉新药、高档药的抗菌谱、适应症、不良反应、配伍禁忌等。
21、 21.抗生素使用原则-抗生素配伍要合理:两种抗生素同时应用,尤其要考虑有无理化、药理等配伍禁忌。